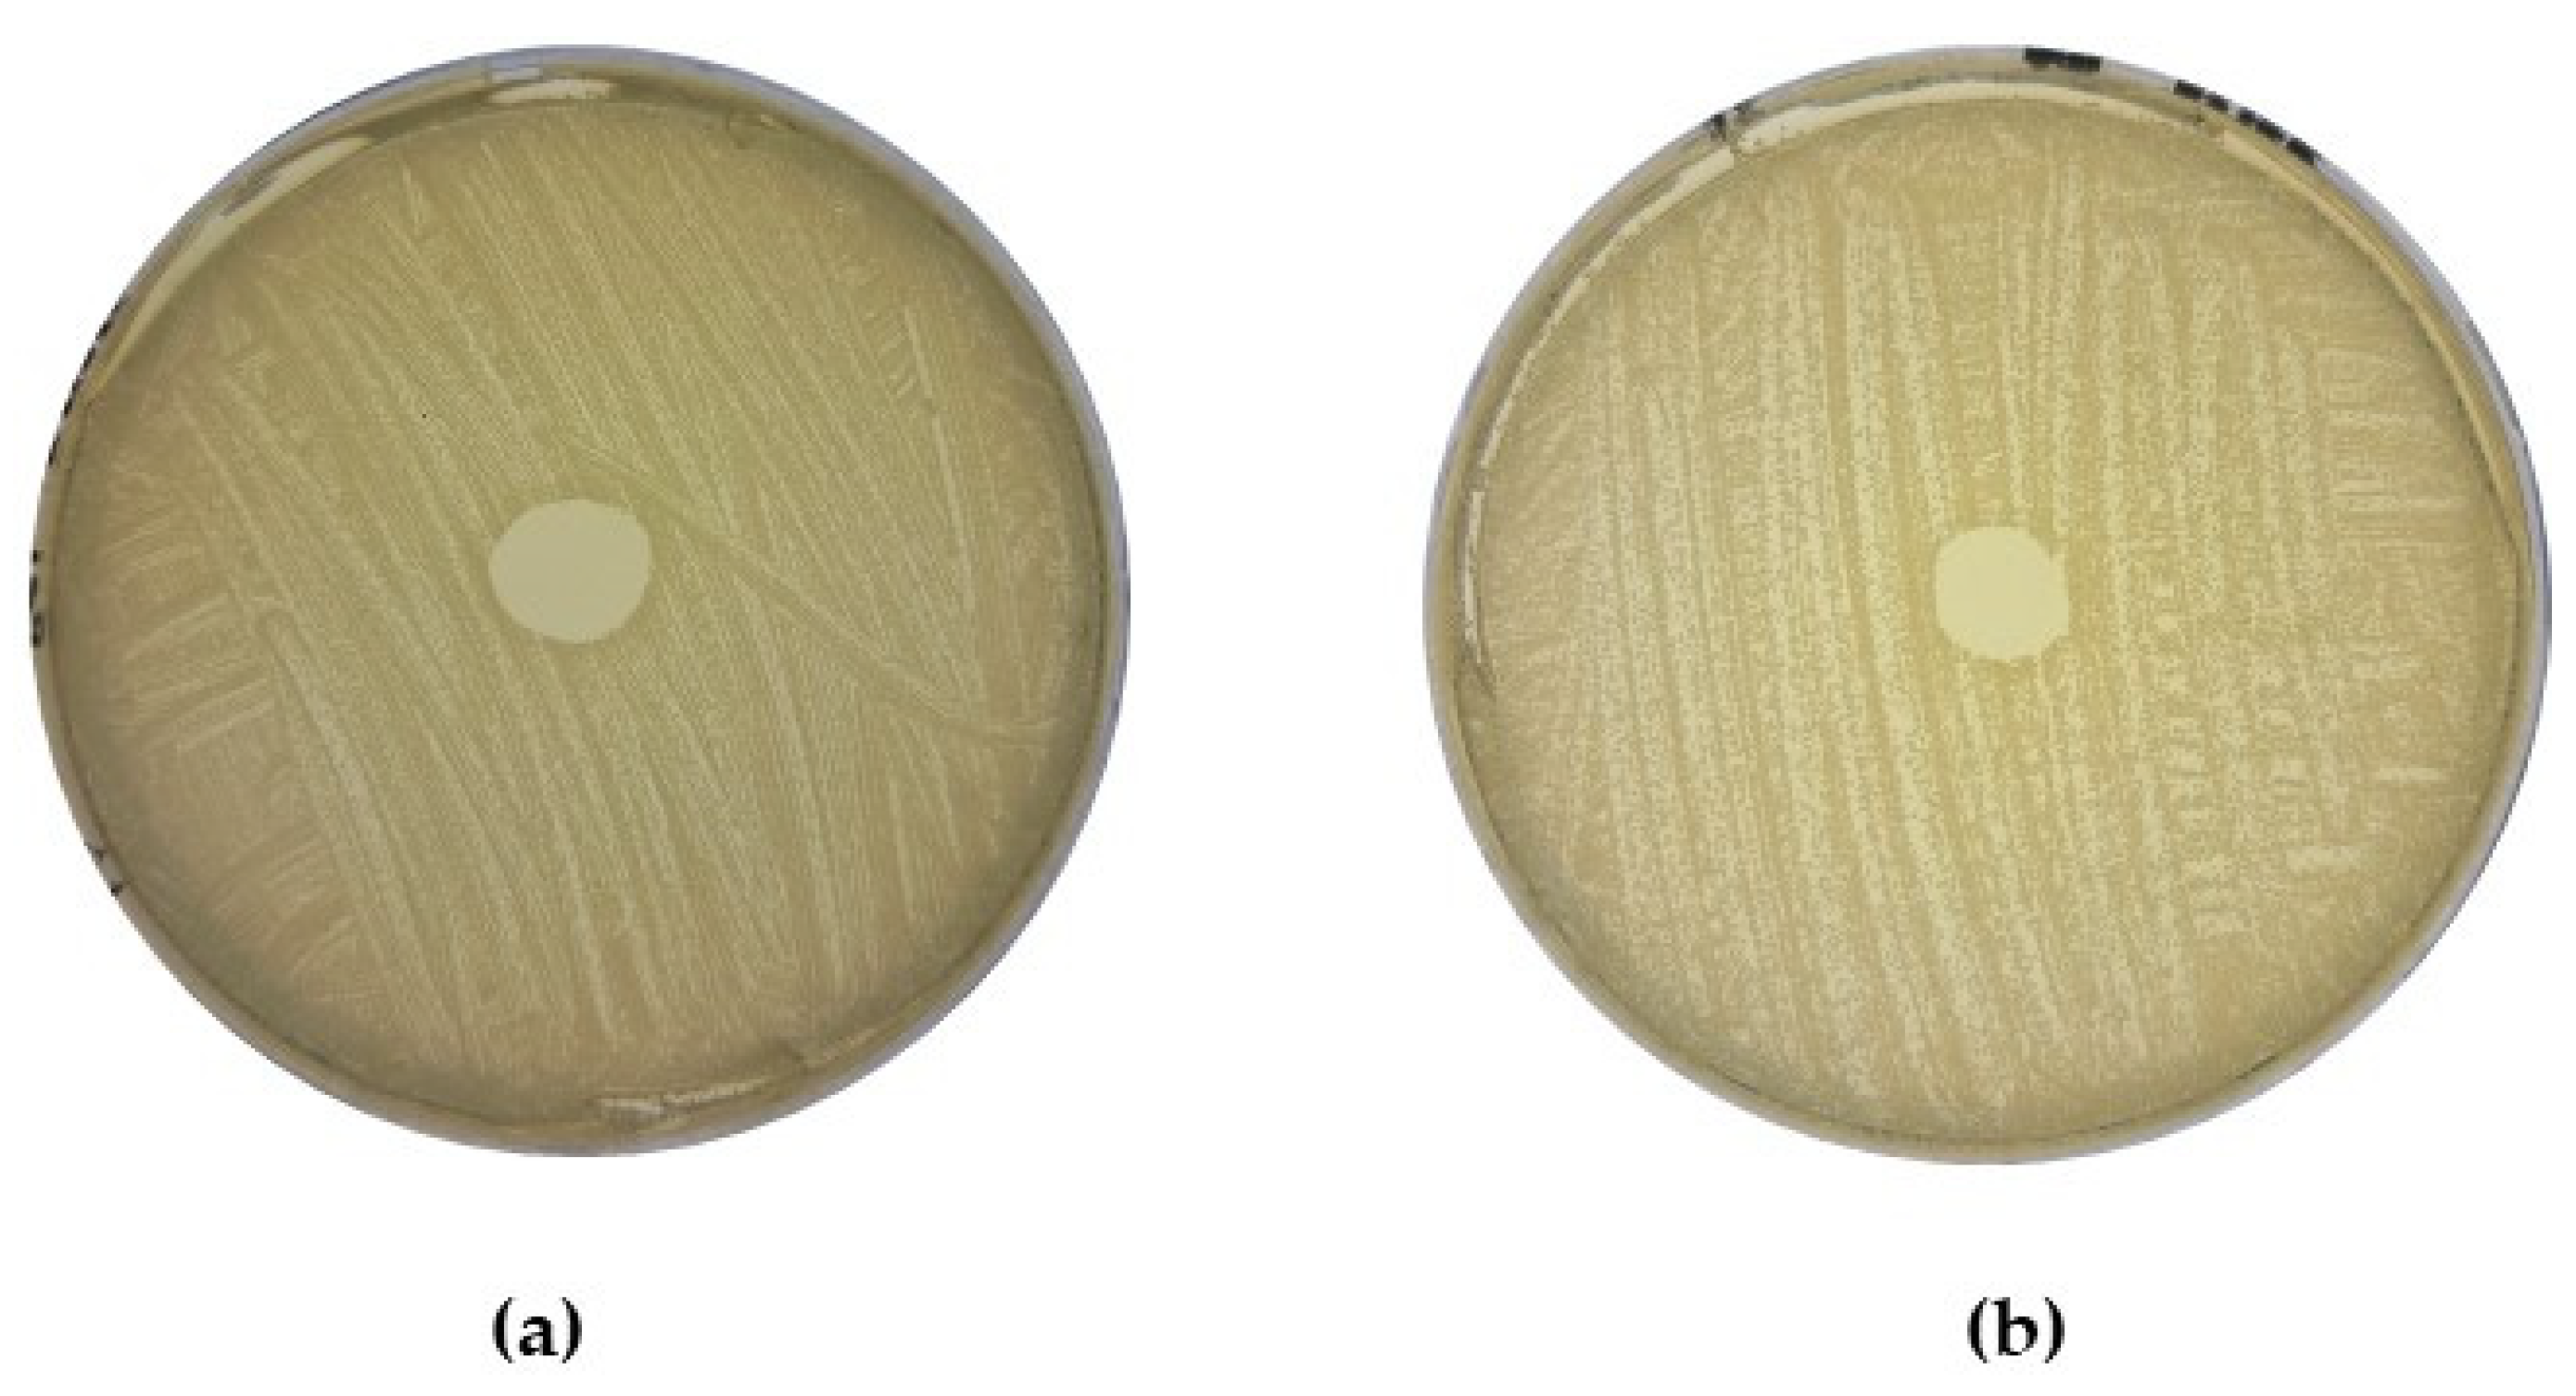
Antibiotics 13 00338 g009

Inhibition of Clinical MRSA Isolates by Coagulase Negative Staphylococci of Human Origin
Abstract
1. Introduction
2. Results
2.1. Identification of CoNS Isolates with Potential Antimicrobial Activity against MRSA
2.2. Examination of the Ability of MRSA to Form Biofilms
2.3. Determination of Direct Antagonism against MRSA by CoNS
2.4. Examination of Potential AntibiofilmEeffects within the Bank of CoNS Isolates
2.5. Analysis of Whole Genome Sequencing of Shortlisted CoNS Isolates
2.6. Purification and Analysis of the Bacteriocins Produced by the Human-Derived CoNS
3. Discussion
4. Materials and Methods
4.1. Bacterial Strains
4.2. Agar-Based Deferred Antagonism Assays to Identify CoNS Isolates with Potential Antimicrobial Activity against Methicillin-Resistant Staphylococcus aureus
4.3. Investigating the Presence of Antimicrobial Activity in Cell-Free Supernatant
4.4. Biofilm Formation Assay
4.5. Assessing the Antimicrobial Activity of the Acid Neutralized CFS of CoNS Isolates against Strain MRSA M
4.6. Biofilm Inhibition Assay
4.7. Whole Genome Sequencing of Selected Coagulase Negative Staphylococcus Isolates
4.8. Analysis of Putative Bacteriocin Clusters Identified in CoNS Isolates
4.9. Purification of Identified Bacteriocins and Investigation of Antimicrobial Activity
5. Conclusions
Supplementary Materials
Author Contributions
Funding
Institutional Review Board Statement
Informed Consent Statement
Data Availability Statement
Acknowledgments
Conflicts of Interest
References
- Zafari, M.; Adibi, M.; Chiani, M.; Bolourchi, N.; Barzi, S.M.; Shams Nosrati, M.S.; Bahari, Z.; Shirvani, P.; Noghabi, K.A.; Ebadi, M.; et al. Effects of cefazolin-containing niosome nanoparticles against methicillin-resistant Staphylococcus aureus biofilm formed on chronic wounds. Biomed. Mater. 2021, 16, 035001. [Google Scholar] [CrossRef]
- Vella, V.; Galgani, I.; Polito, L.; Arora, A.K.; Creech, C.B.; David, M.Z.; Lowy, F.D.; Macesic, N.; Ridgway, J.P.; Uhlemann, A.C.; et al. Staphylococcus aureus skin and soft tissue infection recurrence rates in outpatients: A retrospective database study at 3 US medical centers. Clin. Infect. Dis. Off. Publ. Infect. Dis. Soc. Am. 2021, 73, E1045–E1053. [Google Scholar] [CrossRef] [PubMed]
- Chegini, Z.; Didehdar, M.; Khoshbayan, A.; Karami, J.; Yousefimashouf, M.; Shariati, A. The role of Staphylococcus aureus enterotoxin B in chronic rhinosinusitis with nasal polyposis. Cell Commun. Signal. 2022, 20, 29. [Google Scholar] [CrossRef]
- Tomczak, H.; Wróbel, J.; Jenerowicz, D.; Sadowska-Przytocka, A.; Wachal, M.; Adamski, Z.; Czarnecka-Operacz, M.M. The role of Staphylococcus aureus in atopic dermatitis: Microbiological and immunological implications. Adv. Dermatol. Allergol. 2019, 36, 485. [Google Scholar] [CrossRef]
- World Health Organisation. WHO’s First Global Report on Antibiotic Resistance Reveals Serious, Worldwide Threat to Public Health. 2014. Available online: https://www.who.int/news/item/30-04-2014-who-s-first-global-report-on-antibiotic-resistance-reveals-serious-worldwide-threat-to-public-health (accessed on 31 May 2023).
- Antimicrobial Resistance Collaborators. Global burden of bacterial antimicrobial resistance in 2019: A systematic analysis. Lancet 2022, 399, 629–655. [Google Scholar] [CrossRef] [PubMed]
- Köck, R.; Becker, K.; Cookson, B.; van Gemert-Pijnen, J.E.; Harbarth, S.; Kluytmans, J.; Mielke, M.; Peters, G.; Skov, R.L.; Struelens, M.J.; et al. Systematic literature analysis and review of targeted preventive measures to limit healthcare-associated infections by methicillin-resistant Staphylococcus aureus. Eurosurveillance ECDC 2014, 19, 20860. [Google Scholar] [CrossRef]
- World Health Organisation. Global Priority List of Antibiotic-Resistant Bacteria to Guide Research, Discovery, and Development of New Antibiotics. 2017. Available online: https://www.quotidianosanita.it/allegati/allegato4135670.pdf (accessed on 23 July 2022).
- World Health Organisation. WHO Publishes List of Bacteria for Which New Antibiotics Are Urgently Needed. 2017. Available online: https://www.who.int/news/item/27-02-2017-who-publishes-list-of-bacteria-for-which-new-antibiotics-are-urgently-needed (accessed on 6 April 2021).
- Iwase, T.; Uehara, Y.; Shinji, H.; Tajima, A.; Seo, H.; Takada, K.; Agata, T.; Mizunoe, Y. Staphylococcus epidermidis Esp inhibits Staphylococcus aureus biofilm formation and nasal colonization. Nature 2010, 465, 346–349. [Google Scholar] [CrossRef] [PubMed]
- Cogen, A.L.; Yamasaki, K.; Sanchez, K.M.; Dorschner, R.A.; Lai, Y.; MacLeod, D.T.; Torpey, J.W.; Otto, M.; Nizet, V.; Kim, J.E.; et al. Selective antimicrobial action is provided by phenol-soluble modulins derived from Staphylococcus epidermidis, a normal resident of the skin. J. Investig. Dermatol. 2010, 130, 192–200. [Google Scholar] [CrossRef]
- Park, B.; Iwase, T.; Liu, G.Y. Intranasal application of S. epidermidis prevents colonization by methicillin-resistant Staphylococcus aureus in mice. PLoS ONE 2011, 6, e25880. [Google Scholar] [CrossRef]
- Benítez-Chao, D.F.; León-Buitimea, A.; Lerma-Escalera, J.A.; Morones-Ramírez, J.R. Bacteriocins: An overview of antimicrobial, toxicity, and biosafety assessment by in vivo models. Front. Microbiol. 2021, 12, 630695. [Google Scholar] [CrossRef]
- O’Sullivan, J.N.; O’Connor, P.M.; Rea, M.C.; O’Sullivan, O.; Walsh, C.J.; Healy, B.; Mathur, H.; Field, D.; Hill, C.; Ross, R.P. Nisin J, a novel natural nisin variant, is produced by Staphylococcus capitis sourced from the human skin microbiota. J. Bacteriol. 2020, 202, e00639-19. [Google Scholar] [CrossRef] [PubMed]
- Halliwell, S.; Warn, P.; Sattar, A.; Derrick, J.P.; Upton, M. A single dose of epidermicin NI01 is sufficient to eradicate MRSA from the nares of cotton rats. J. Antimicrob. Chemother. 2017, 72, 778–781. [Google Scholar] [CrossRef]
- Kadariya, J.; Thapaliya, D.; Bhatta, S.; Mahatara, R.L.; Bempah, S.; Dhakal, N.; Smith, T.C. Multidrug-resistant Staphylococcus aureus colonization in healthy adults is more common in Bhutanese refugees in Nepal than those resettled in Ohio. BioMed Res. Int. Hindawi 2019, 5739247. [Google Scholar] [CrossRef] [PubMed]
- Kot, B.; Wierzchowska, K.; Piechota, M.; Grużewska, A. Antimicrobial resistance patterns in methicillin-resistant Staphylococcus aureus from patients hospitalized during 2015–2017 in hospitals in Poland. Med. Princ. Pract. 2020, 29, 61–68. [Google Scholar] [CrossRef]
- Lecai, J.; Mijiti, P.; Chuangyue, H.; Mingzhen, L.; Qian, G.; Weiguo, T.; Jihong, C. Predictors and trends of MDR/RR-TB in Shenzhen China: A retrospective 2012–2020 period analysis. Infect. Drug Resist. 2021, 14, 4481. [Google Scholar] [CrossRef]
- Mathur, T.; Singhal, S.; Khan, S.; Upadhyay, D.J.; Fatma, T.; Rattan, A. Detection of biofilm formation among the clinical isolates of staphylococci: An evaluation of three different screening methods. Indian J. Med. Microbiol. 2006, 24, 25–34. [Google Scholar] [CrossRef] [PubMed]
- Peng, P.; Baldry, M.; Gless, B.H.; Bojer, M.S.; Espinosa-Gongora, C.; Baig, S.J.; Andersen, P.S.; Olsen, C.A.; Ingmer, H. Effect of co-inhabiting coagulase negative staphylococci on S. aureus agr quorum sensing, host factor binding, and biofilm formation. Front. Microbiol. 2019, 10, 02212. [Google Scholar] [CrossRef]
- Paharik, A.E.; Parlet, C.P.; Chung, N.; Todd, D.A.; Rodriguez, E.I.; Van Dyke, M.J.; Cech, N.B.; Horswill, A.R. ‘Coagulase-negative staphylococcal strain prevents Staphylococcus aureus colonization and skin infection by blocking quorum sensing. Cell Host Microbe 2017, 22, 746–756.e5. [Google Scholar] [CrossRef] [PubMed]
- Kumari, A.; Tewari, R.; Singh, R. Antagonistic interaction of Staphylococcus aureus and Staphylococcus epidermidis with Rhizopus arrhizus Mediated by phenol soluble modulins and organic acids. ACS Infect. Dis. 2019, 5, 1887–1895. [Google Scholar] [CrossRef]
- Deeyagahage, K.; Ruzzini, A. Cell-penetrating antimicrobial peptides derived from an atypical staphylococcal δ-toxin. Microbiol. Spectr. 2021, 9, e0158421. [Google Scholar] [CrossRef]
- Cogen, A.; Yamasaki, K.; Muto, J.; Sanchez, K.M.; Alexander, L.C.; Tanios, J.; Lai, Y.; Kim, J.E.; Nizet, V.; Gallo, R.L. Staphylococcus epidermidis antimicrobial delta-toxin (phenol-soluble modulin-gamma) cooperates with host antimicrobial peptides to kill group A Streptococcus. PLoS ONE 2010, 5, e8557. [Google Scholar] [CrossRef]
- Götz, F.; Perconti, S.; Popella, P.; Werner, R.; Schlag, M. Epidermin and gallidermin: Staphylococcal lantibiotics. Int. J. Med. Microbiol. 2014, 304, 63–71. [Google Scholar] [CrossRef]
- Kim, P.I.; Sohng, J.K.; Sung, C.; Joo, H.S.; Kim, E.M.; Yamaguchi, T.; Park, D.; Kim, B.G. ‘Characterization and structure identification of an antimicrobial peptide, hominicin, produced by Staphylococcus hominis MBBL 2–9. Biochem. Biophys. Res. Commun. 2010, 399, 133–138. [Google Scholar] [CrossRef] [PubMed]
- Wilaipun, P.; Zendo, T.; Okuda, K.; Nakayama, J.; Sonomoto, K. Identification of the nukacin KQU-131, a new type-A(II) lantibiotic produced by Staphylococcus hominis KQU-131 Isolated from Thai Fermented Fish Product (Pla-ra). Biosci. Biotechnol. Biochem. 2014, 72, 2232–2235. [Google Scholar] [CrossRef] [PubMed]
- Ekkelenkamp, M.B.; Hanssen, M.; Danny Hsu, S.T.; de Jong, A.; Milatovic, D.; Verhoef, J.; van Nuland, N.A. Isolation and structural characterization of epilancin 15X, a novel lantibiotic from a clinical strain of Staphylococcus epidermidis. FEBS Lett. 2005, 579, 1917–1922. [Google Scholar] [CrossRef] [PubMed]
- Angelopoulou, A.; Warda, A.K.; O’Connor, P.M.; Stockdale, S.R.; Shkoporov, A.N.; Field, D.; Draper, L.A.; Stanton, C.; Hill, C.; Ross, R.P. Diverse bacteriocins produced by strains from the human milk microbiota. Front. Microbiol. 2020, 11, 788. [Google Scholar] [CrossRef]
- Velásquez, J.E.; Zhang, X.; van der Donk, W. Biosynthesis of the antimicrobial peptide epilancin 15X and its N-terminal lactate. Chem. Biol. 2011, 18, 857–867. [Google Scholar] [CrossRef]
- Wanke, I.; Steffen, H.; Christ, C.; Krismer, B.; Götz, F.; Peschel, A.; Schaller, M.; Schittek, B. Skin commensals amplify the innate immune response to pathogens by activation of distinct signaling pathways. J. Investig. Dermatol. 2011, 131, 382–390. [Google Scholar] [CrossRef]
- Burian, M.; Bitschar, K.; Dylus, B.; Peschel, A.; Schittek, B. The protective effect of microbiota on S. aureus skin colonization depends on the integrity of the epithelial barrier. J. Investig. Dermatol. 2017, 137, 976–979. [Google Scholar] [CrossRef]
- Bitschar, K.; Staudenmaier, L.; Klink, L.; Focken, J.; Sauer, B.; Fehrenbacher, B.; Herster, F.; Bittner, Z.; Bleul, L.; Schaller, M.; et al. Staphylococcus aureus skin colonization is enhanced by the interaction of neutrophil extracellular traps with keratinocytes. J. Investig. Dermatol. 2020, 140, 1054–1065.e4. [Google Scholar] [CrossRef]
- Bastos, M.D.; Coutinho, B.G.; Coelho, M.L. Lysostaphin: A staphylococcal bacteriolysin with potential clinical applications. Pharmaceuticals 2010, 3, 1139–1161. [Google Scholar] [CrossRef] [PubMed]
- Cheleuitte-Nieves, C.E.; Diaz, L.L.; Pardos de la Gandara, M.; Gonzalez, A.; Freiwald, W.A.; de Lencastre, H.M.; Tomasz, A.; Euler, C.W. Evaluation of topical lysostaphin as a novel treatment for instrumented Rhesus Macaques (Macaca mulatta) infected with Methicillin-Resistant Staphylococcus aureus. J. Comp. Med. 2020, 70, 335–347. [Google Scholar] [CrossRef] [PubMed]
- Lynch, D.; O’Connor, P.M.; Cotter, P.D.; Hill, C.; Field, D.; Begley, M. Identification and characterization of capidermicin, a novel bacteriocin produced by Staphylococcus capitis. PLoS ONE 2019, 14, e0223541. [Google Scholar] [CrossRef] [PubMed]
- Newstead, L.L.; Varjonen, K.; Nuttall, T.; Paterson, G.K. Staphylococcal-produced bacteriocins and antimicrobial peptides: Their potential as alternative treatments for Staphylococcus aureus infections. Antibiotics 2020, 9, 40. [Google Scholar] [CrossRef] [PubMed]
- O’Sullivan, J.N.; Rea, M.C.; O’Connor, P.M.; Hill, C.; Ross, R.P. Human skin microbiota is a rich source of bacteriocin-producing staphylococci that kill human pathogens. FEMS Microbiol. Ecol. 2019, 95, 241. [Google Scholar] [CrossRef] [PubMed]
- Janek, D.; Zipperer, A.; Kulik, A.; Krismer, B.; Peschel, A. High frequency and diversity of antimicrobial activities produced by nasal Staphylococcus strains against bacterial competitors. PLoS Pathog. 2016, 12, e1005812. [Google Scholar] [CrossRef]
- Kassem, M.A.; Saafan, A.E.; Bayomy, F.; El-Gendy, A.O. Exploring clinically isolated Staphylococcus sp. bacteriocins revealed the production of amonabactin, micrococcin, and α-circulocin. Iran. J. Microbiol. 2021, 13, 212–224. [Google Scholar] [CrossRef]
- Chin, D.; Goncheva, M.I.; Flannagan, R.S.; Deecker, S.R.; Guariglia-Oropeza, V.; Ensminger, A.W.; Heinrichs, D.E. Coagulase-negative staphylococci release a purine analog that inhibits Staphylococcus aureus virulence. Nat. Commun. 2021, 12, 1887. [Google Scholar] [CrossRef]
- Marković, K.G.; Grujović, M.Ž.; Koraćević, M.G.; Nikodijević, D.D.; Milutinović, M.G.; Semedo-Lemsaddek, T.; Djilas, M.D. Colicins and microcins produced by Enterobacteriaceae: Characterization, mode of action, and putative applications. Int. J. Environ. Res. Public Health 2022, 19, 11825. [Google Scholar] [CrossRef]
- U.S. Food and Drug Administration. Title 21—Food and Drugs Chapter I--Food and Drug Administration Department of Health and Human Services Subchapter B—Food for Human Consumption (CONTINUED) Part 184—Direct Food Substances Affirmed as Generally Recognised as Safe Subpart B. 2019. Available online: https://www.accessdata.fda.gov/scripts/cdrh/cfdocs/cfcfr/CFRSearch.cfm?fr=184.1538 (accessed on 6 April 2021).
- Cheung GY, C.; Joo, H.S.; Chatterjee, S.S.; Otto, M. Phenol-soluble modulins—Critical determinants of staphylococcal virulence. FEMS Microbiol. Rev. 2014, 38, 698–719. [Google Scholar] [CrossRef]
- Brüggemann, H.; Poehlein, A.; Brzuszkiewicz, E.; Scavenius, C.; Enghild, J.J.; Al-Zeer, M.A.; Brinkmann, V.; Jensen, A.; Söderquist, B. Staphylococcus saccharolyticus isolated from blood cultures and prosthetic joint infections exhibits excessive genome decay. Front. Microbiol. 2019, 10, 478. [Google Scholar] [CrossRef] [PubMed]
- Guinane, C.M.; Ben Zakour, N.L.; Tormo-Mas, M.A.; Weinert, L.A.; Lowder, B.V.; Cartwright, R.A.; Smyth, D.S.; Smyth, C.J.; Lindsay, J.A.; Gould, K.A.; et al. Evolutionary genomics of Staphylococcus aureus reveals insights into the origin and molecular basis of ruminant host adaptation. Genome Biol. Evol. 2010, 2, 454–466. [Google Scholar] [CrossRef] [PubMed]
- Nakazono, K.; Le, M.N.; Kawada-Matsuo, M.; Kimheang, N.; Hisatsune, J.; Oogai, Y.; Nakata, M.; Nakamura, N.; Sugai, M.; Komatsuzawa, H. Complete sequences of epidermin and nukacin encoding plasmids from oral-derived Staphylococcus epidermidis and their antibacterial activity. PLoS ONE 2022, 17, e0258283. [Google Scholar] [CrossRef]
- Okuda, K.; Zendo, T.; Sugimoto, S.; Iwase, T.; Tajima, A.; Yamada, S.; Sonomoto, K.; Mizunoe, Y. Effects of bacteriocins on methicillin-resistant Staphylococcus aureus biofilm. Antimicrob. Agents Chemother. 2013, 57, 5572–5579. [Google Scholar] [CrossRef]
- van de Kamp, M.; van den Hooven, H.W.; Konings, R.N.; Bierbaum, G.; Sahl, H.G.; Kuipers, O.P.; Siezen, R.J.; de Vos, W.M.; Hilbers, C.W.; van de Ven, F.J. Elucidation of the primary structure of the lantibiotic epilancin K7 from Staphylococcus epidermidis K7. Cloning and characterisation of the epilancin-K7-encoding gene and NMR analysis of mature epilancin K7. Eur. J. Biochem. 1995, 230, 587–600. [Google Scholar] [CrossRef]
- Immucell. RE-TAIN™: Purified Nisin Intramammary Treatment for Mastitis. 2022. Available online: https://immucell.com/re-tain/ (accessed on 31 May 2023).
- Globe Newswire. ImmuCell Receives Technical Section Incomplete Letter from FDA Pertaining to Re-Tain®. 2022. Available online: https://www.globenewswire.com/en/news-release/2022/07/28/2487422/0/en/ImmuCell-Receives-Technical-Section-Incomplete-Letter-from-FDA-Pertaining-to-Re-Tain.html (accessed on 31 May 2023).
- Bitschar, K.; Sauer, B.; Focken, J.; Dehmer, H.; Moos, S.; Konnerth, M.; Schilling, N.A.; Grond, S.; Kalbacher, H.; Kurschus, F.C.; et al. Lugdunin amplifies innate immune responses in the skin in synergy with host- and microbiota-derived factors. Nat. Commun. 2019, 10, 2730. [Google Scholar] [CrossRef]
- Gibreel, T.M.; Upton, M. Synthetic epidermicin NI01 can protect Galleria mellonella larvae from infection with Staphylococcus aureus. J. Antimicrob. Chemother. 2013, 68, 2269–2273. [Google Scholar] [CrossRef] [PubMed]
- Bramley, A.J.; Foster, R. Effects of lysostaphin on Staphylococcus aureus infections of the mouse mammary gland. Res. Vet. Sci. 1990, 49, 120–121. [Google Scholar] [CrossRef]
- Piper, C.; Casey, P.G.; Hill, C.; Cotter, P.D.; Ross, R.P. The lantibiotic lacticin 3147 prevents systemic spread of Staphylococcus aureus in a murine infection model. Int. J. Microbiol. 2012, 2012, 806230. [Google Scholar] [CrossRef]
- Zhao, X.; Kuipers, O.P. Synthesis of silver-nisin nanoparticles with low cytotoxicity as antimicrobials against biofilm-forming pathogens. Colloids Surf. B Biointerfaces 2021, 206, 111965. [Google Scholar] [CrossRef]
- Rea, M.C.; Alemayehu, D.; Casey, P.G.; O’Connor, P.M.; Lawlor, P.G.; Walsh, M.; Shanahan, F.; Kiely, B.; Ross, R.P.; Hill, C. Bioavailability of the anti-clostridial bacteriocin thuricin CD in gastrointestinal tract. Microbiology (United Kingdom). Microbiol. Soc. 2014, 160, 439–445. [Google Scholar] [CrossRef]
- Field, D.; O’Connor, R.; Cotter, P.D.; Ross, R.P.; Hill, C. In vitro activities of nisin and nisin derivatives alone and in combination with antibiotics against Staphylococcus biofilms. Front. Microbiol. 2016, 7, 508. [Google Scholar] [CrossRef] [PubMed]
- Ellis, J.-C.; Ross, R.P.; Hill, C. Nisin Z and lacticin 3147 improve efficacy of antibiotics against clinically significant bacteria. Future Microbiol. 2019, 14, 1573–1587. [Google Scholar] [CrossRef] [PubMed]
- Gomes, D.; Santos, R.S.; Soares, R.; Reis, S.; Carvalho, S.; Rego, P.C.; Peleteiro, M.; Tavares, L.; Oliveira, M. Pexiganan in combination with nisin to control polymicrobial diabetic foot infections. Antibiotics 2020, 9, 128. [Google Scholar] [CrossRef] [PubMed]
- Lynch, D.; Hill, C.; Field, D.; Begley, M. Inhibition of Listeria monocytogenes by the Staphylococcus capitis—derived bacteriocin capidermicin. Food Microbiol. 2021, 94, 103661. [Google Scholar] [CrossRef] [PubMed]
- St. James National MRSA Reference Laboratory. Annual Report 2020. 2020. Available online: https://www.stjames.ie/media/AnnRpt2020.pdf (accessed on 22 July 2022).
- McManus, B.A.; Aloba, B.K.; Earls, M.R.; Brennan, G.I.; O’Connell, B.; Monecke, S.; Ehricht, R.; Shore, A.C.; Coleman, D.C. Multiple distinct outbreaks of Panton–Valentine leucocidin-positive community-associated methicillin-resistant Staphylococcus aureus in Ireland investigated by whole-genome sequencing. Journal of Hospital Infection 2021, 108, 72–80. [Google Scholar] [CrossRef] [PubMed]
- Roe, C.; Stegger, M.; Lilje, B.; Johannesen, T.B.; Ng, K.L.; Sieber, R.N.; Driebe, E.; Engelthaler, D.M.; Andersen, P.S. Genomic analyses of Staphylococcus aureus clonal complex 45 isolates does not distinguish nasal carriage from bacteremia. Microb. Genom. 2020, 6, mgen000403. [Google Scholar] [CrossRef] [PubMed]
- Stepanović, S.; Vuković, D.; Hola, V.; Di Bonaventura, G.; Djukić, S.; Cirković, I.; Ruzicka, F. Quantification of biofilm in microtiter plates: Overview of testing conditions and practical recommendations for assessment of biofilm production by staphylococci. APMIS. Blackwell Munksgaard 2007, 115, 891–899. [Google Scholar] [CrossRef] [PubMed]
- Vijayakumar, P.; Muriana, P. A microplate growth inhibition assay for screening bacteriocins against Listeria monocytogenes to differentiate their mode-of-action. Biomolecules 2015, 5, 1178–1194. [Google Scholar] [CrossRef]
- Field, D.; Begley, M.; O’Connor, P.M.; Daly, K.M.; Hugenholtz, F.; Cotter, P.D.; Hill, C.; Ross, R.P. Bioengineered nisin A derivatives with enhanced activity against both gram positive and gram-negative pathogens. PLoS ONE 2012, 7, 10. [Google Scholar] [CrossRef]


 ) represents the positive control in each assay (MRSA cultured in the absence of CFS), and patterned bars represent an MRSA strain cultured in the presence of CFS. The effect of the CFS was investigated against 5 MRSA indicators (a) V, (b) R, (c) M, (d) T, and (e) E. The MRSA strains were cultured for 24 h at 37 °C under stationary conditions in the presence of 100 µL of acid-neutralized CFS. The absorbance of MRSA cultured in the presence of CFS was compared to the positive control. Asterixis indicates a significant difference in biofilm formed when compared to the control, where *** denotes a reduction of p < 0.001, ** denotes a reduction of p < 0.01, and * denotes a reduction of p < 0.05. In contrast, “-” denotes a non-statistically significant reduction, no change, or an increase in biofilm formation.
) represents the positive control in each assay (MRSA cultured in the absence of CFS), and patterned bars represent an MRSA strain cultured in the presence of CFS. The effect of the CFS was investigated against 5 MRSA indicators (a) V, (b) R, (c) M, (d) T, and (e) E. The MRSA strains were cultured for 24 h at 37 °C under stationary conditions in the presence of 100 µL of acid-neutralized CFS. The absorbance of MRSA cultured in the presence of CFS was compared to the positive control. Asterixis indicates a significant difference in biofilm formed when compared to the control, where *** denotes a reduction of p < 0.001, ** denotes a reduction of p < 0.01, and * denotes a reduction of p < 0.05. In contrast, “-” denotes a non-statistically significant reduction, no change, or an increase in biofilm formation.
 ) represents the positive control in each assay (MRSA cultured in the absence of CFS), and patterned bars represent an MRSA strain cultured in the presence of CFS. The effect of the CFS was investigated against 5 MRSA indicators (a) V, (b) R, (c) M, (d) T, and (e) E. The MRSA strains were cultured for 24 h at 37 °C under stationary conditions in the presence of 100 µL of acid-neutralized CFS. The absorbance of MRSA cultured in the presence of CFS was compared to the positive control. Asterixis indicates a significant difference in biofilm formed when compared to the control, where *** denotes a reduction of p < 0.001, ** denotes a reduction of p < 0.01, and * denotes a reduction of p < 0.05. In contrast, “-” denotes a non-statistically significant reduction, no change, or an increase in biofilm formation.
) represents the positive control in each assay (MRSA cultured in the absence of CFS), and patterned bars represent an MRSA strain cultured in the presence of CFS. The effect of the CFS was investigated against 5 MRSA indicators (a) V, (b) R, (c) M, (d) T, and (e) E. The MRSA strains were cultured for 24 h at 37 °C under stationary conditions in the presence of 100 µL of acid-neutralized CFS. The absorbance of MRSA cultured in the presence of CFS was compared to the positive control. Asterixis indicates a significant difference in biofilm formed when compared to the control, where *** denotes a reduction of p < 0.001, ** denotes a reduction of p < 0.01, and * denotes a reduction of p < 0.05. In contrast, “-” denotes a non-statistically significant reduction, no change, or an increase in biofilm formation.

 ) represents the genes encoding immunity peptides gdmGFE, (
) represents the genes encoding immunity peptides gdmGFE, ( ) represents the genes encoding transport/export proteins gdmHT, (
) represents the genes encoding transport/export proteins gdmHT, ( ) represents the gene encoding the core pre-peptide, (
) represents the gene encoding the core pre-peptide, ( ) represents modification genes gdmBCD (
) represents modification genes gdmBCD ( ) represents regulation/activator gene gdmQ, and (
) represents regulation/activator gene gdmQ, and ( ) represents processing gene gdmP. Genes with a corresponding function in the AOIs identified in isolates E4, E96, and E170 are highlighted in the same color. In the putative bacteriocin operons identified in isolates E4, E96, and E170 (
) represents processing gene gdmP. Genes with a corresponding function in the AOIs identified in isolates E4, E96, and E170 are highlighted in the same color. In the putative bacteriocin operons identified in isolates E4, E96, and E170 ( ) represents hypothetical proteins, and (
) represents hypothetical proteins, and ( ) represents putative lipoproteins. (b) The amino acid sequences encoding the gallidermin pre-peptide (gdmA) and the presumptive core peptides identified in the AOIs detected in isolate E4, E96, and E170 by BAGEL4.0.
) represents putative lipoproteins. (b) The amino acid sequences encoding the gallidermin pre-peptide (gdmA) and the presumptive core peptides identified in the AOIs detected in isolate E4, E96, and E170 by BAGEL4.0.
 ) represents the genes encoding immunity peptides gdmGFE, (
) represents the genes encoding immunity peptides gdmGFE, ( ) represents the genes encoding transport/export proteins gdmHT, (
) represents the genes encoding transport/export proteins gdmHT, ( ) represents the gene encoding the core pre-peptide, (
) represents the gene encoding the core pre-peptide, ( ) represents modification genes gdmBCD (
) represents modification genes gdmBCD ( ) represents regulation/activator gene gdmQ, and (
) represents regulation/activator gene gdmQ, and ( ) represents processing gene gdmP. Genes with a corresponding function in the AOIs identified in isolates E4, E96, and E170 are highlighted in the same color. In the putative bacteriocin operons identified in isolates E4, E96, and E170 (
) represents processing gene gdmP. Genes with a corresponding function in the AOIs identified in isolates E4, E96, and E170 are highlighted in the same color. In the putative bacteriocin operons identified in isolates E4, E96, and E170 ( ) represents hypothetical proteins, and (
) represents hypothetical proteins, and ( ) represents putative lipoproteins. (b) The amino acid sequences encoding the gallidermin pre-peptide (gdmA) and the presumptive core peptides identified in the AOIs detected in isolate E4, E96, and E170 by BAGEL4.0.
) represents putative lipoproteins. (b) The amino acid sequences encoding the gallidermin pre-peptide (gdmA) and the presumptive core peptides identified in the AOIs detected in isolate E4, E96, and E170 by BAGEL4.0.
 ) represents regulation gene orf1 (
) represents regulation gene orf1 ( ) represents the core pre-peptide gene (
) represents the core pre-peptide gene ( ) represents modification peptide nukM (
) represents modification peptide nukM ( ) represents transport and permease genes nukTFEG, and (
) represents transport and permease genes nukTFEG, and ( ) represents hypothetical protein nukH. Genes with a corresponding function in the AOI detected in S. hominis C14 are highlighted in the same color. (b) Alignment of the amino acid sequence of the nukacin KQU-131 pre-peptide and that of the putative core peptide sequence identified in S. hominis C14.
) represents hypothetical protein nukH. Genes with a corresponding function in the AOI detected in S. hominis C14 are highlighted in the same color. (b) Alignment of the amino acid sequence of the nukacin KQU-131 pre-peptide and that of the putative core peptide sequence identified in S. hominis C14.
 ) represents regulation gene orf1 (
) represents regulation gene orf1 ( ) represents the core pre-peptide gene (
) represents the core pre-peptide gene ( ) represents modification peptide nukM (
) represents modification peptide nukM ( ) represents transport and permease genes nukTFEG, and (
) represents transport and permease genes nukTFEG, and ( ) represents hypothetical protein nukH. Genes with a corresponding function in the AOI detected in S. hominis C14 are highlighted in the same color. (b) Alignment of the amino acid sequence of the nukacin KQU-131 pre-peptide and that of the putative core peptide sequence identified in S. hominis C14.
) represents hypothetical protein nukH. Genes with a corresponding function in the AOI detected in S. hominis C14 are highlighted in the same color. (b) Alignment of the amino acid sequence of the nukacin KQU-131 pre-peptide and that of the putative core peptide sequence identified in S. hominis C14.
 ) represents modification gene elxO (
) represents modification gene elxO ( ) represents transport gene exlT (
) represents transport gene exlT ( ) represents the gene for the core peptide gene exlA (
) represents the gene for the core peptide gene exlA ( ) represents processing gene exlP (
) represents processing gene exlP ( ) represents bacteriocin biosynthesis gene elxBC, and (
) represents bacteriocin biosynthesis gene elxBC, and ( ) represents immunity genes exlI(1/2/3). Genes with a corresponding function in the C 33 AOI are highlighted in the same color. In the AOI identified in isolate C33 (
) represents immunity genes exlI(1/2/3). Genes with a corresponding function in the C 33 AOI are highlighted in the same color. In the AOI identified in isolate C33 ( ) represents a gene predicted to encode a putative intermembrane-associated protein, potentially involved with bacteriocin immunity. (b) Alignment of the amino acid sequence of the gene encoding the epilancin 15X peptide and that of the gene encoding the putative core peptide detected in isolate C33, where the deviations in the amino acid sequences are highlighted in red.
) represents a gene predicted to encode a putative intermembrane-associated protein, potentially involved with bacteriocin immunity. (b) Alignment of the amino acid sequence of the gene encoding the epilancin 15X peptide and that of the gene encoding the putative core peptide detected in isolate C33, where the deviations in the amino acid sequences are highlighted in red.
 ) represents modification gene elxO (
) represents modification gene elxO ( ) represents transport gene exlT (
) represents transport gene exlT ( ) represents the gene for the core peptide gene exlA (
) represents the gene for the core peptide gene exlA ( ) represents processing gene exlP (
) represents processing gene exlP ( ) represents bacteriocin biosynthesis gene elxBC, and (
) represents bacteriocin biosynthesis gene elxBC, and ( ) represents immunity genes exlI(1/2/3). Genes with a corresponding function in the C 33 AOI are highlighted in the same color. In the AOI identified in isolate C33 (
) represents immunity genes exlI(1/2/3). Genes with a corresponding function in the C 33 AOI are highlighted in the same color. In the AOI identified in isolate C33 ( ) represents a gene predicted to encode a putative intermembrane-associated protein, potentially involved with bacteriocin immunity. (b) Alignment of the amino acid sequence of the gene encoding the epilancin 15X peptide and that of the gene encoding the putative core peptide detected in isolate C33, where the deviations in the amino acid sequences are highlighted in red.
) represents a gene predicted to encode a putative intermembrane-associated protein, potentially involved with bacteriocin immunity. (b) Alignment of the amino acid sequence of the gene encoding the epilancin 15X peptide and that of the gene encoding the putative core peptide detected in isolate C33, where the deviations in the amino acid sequences are highlighted in red.

| Indicator Strain. | ||||||||||||||||||||||
|---|---|---|---|---|---|---|---|---|---|---|---|---|---|---|---|---|---|---|---|---|---|---|
| CoNS Isolate | ML | B | C | D | E | F | G | H | I | J | K | L | M | N | O | P | R | S | T | U | V | W |
| C1 | ++ | − | − | − | − | − | − | − | − | − | − | − | − | − | − | − | − | − | − | − | − | − |
| C4 | + | − | − | − | − | − | − | − | − | + | − | − | − | − | − | − | − | − | − | − | − | − |
| C5 | + | − | − | − | − | − | − | − | − | − | + | + | − | − | − | − | + | − | − | − | − | − |
| C7 | ++ | − | − | − | − | − | − | − | − | − | − | − | − | − | − | − | − | − | − | − | − | − |
| C9 | ++ | − | − | − | − | − | − | − | − | + | − | − | − | − | − | − | − | − | − | − | − | − |
| C14 | +++ | − | − | − | − | − | + | − | − | − | − | − | − | − | − | − | + | − | − | − | − | − |
| C15 | +++ | + | − | − | − | + | − | − | − | − | − | − | − | − | − | − | − | − | − | − | − | − |
| C19 | ++ | − | − | − | − | − | − | − | − | − | − | − | − | − | − | − | − | − | − | − | − | − |
| C20 | + | − | − | − | − | − | − | − | − | − | − | − | − | − | − | − | − | − | − | − | − | − |
| C31 | ++ | − | − | − | − | − | − | − | − | − | − | − | − | − | − | − | − | − | − | − | − | − |
| C32 | ++ | − | − | − | − | − | − | − | − | − | − | − | − | − | − | − | − | − | − | − | − | − |
| C33 | +++ | − | − | − | − | − | − | − | − | − | − | − | − | − | − | − | − | − | − | − | − | − |
| C35 | ++ | − | − | − | − | − | − | − | − | − | − | − | − | − | − | − | − | − | − | − | − | − |
| C39 | ++ | − | − | − | − | − | − | − | − | − | − | − | − | − | − | − | − | − | − | − | − | − |
| C41 | + | − | − | − | − | − | − | − | − | − | − | − | − | − | − | − | − | − | − | − | − | − |
| C42 | ++ | − | − | − | − | − | − | − | − | − | − | − | − | − | − | − | − | − | − | − | − | − |
| C46 | ++ | − | − | − | − | − | − | − | − | − | − | − | − | − | − | − | − | − | − | − | − | − |
| C48 | + | − | − | − | − | − | − | − | − | − | − | − | − | − | − | − | − | − | − | − | − | − |
| C28 | + | − | − | − | − | − | − | − | − | − | − | − | − | − | − | − | − | − | − | − | − | − |
| E3 | ++ | − | − | − | − | − | − | − | − | − | − | − | − | − | − | − | − | − | − | − | − | − |
| E4 | + | − | − | − | − | − | − | − | − | − | − | − | − | − | − | − | − | − | − | − | − | − |
| E6 | ++ | − | − | − | − | − | − | − | − | − | − | − | − | − | − | − | − | − | − | − | − | − |
| E17 | + | − | − | − | − | − | − | − | − | − | − | − | − | − | − | − | − | − | − | − | − | − |
| E46 | ++ | − | − | − | − | − | − | − | − | − | − | − | − | − | − | − | − | − | − | − | − | − |
| E48 | + | − | − | − | − | − | − | − | − | − | − | − | − | − | − | − | − | − | − | − | − | − |
| E54 | + | − | − | − | + | − | − | − | − | − | − | − | − | − | − | − | − | − | − | − | − | − |
| E67 | ++ | − | + | + | + | − | + | + | + | − | + | + | + | + | − | + | + | − | + | + | + | + |
| E72 | + | − | − | − | − | − | − | − | − | − | − | − | − | − | − | − | − | − | − | − | − | − |
| E75 | + | − | − | − | − | − | − | − | − | − | − | − | − | − | − | − | − | − | − | − | − | − |
| E89 | + | − | − | − | − | − | − | − | − | − | − | − | − | − | − | − | − | − | − | − | − | − |
| E96 | + | − | − | − | − | − | − | − | − | − | − | − | − | − | − | − | − | − | − | − | − | − |
| E99 | + | − | − | − | − | − | − | − | − | − | − | − | − | − | − | − | − | − | − | − | − | − |
| E100 | + | − | − | − | − | − | − | − | − | − | − | − | − | − | − | − | − | − | − | − | − | − |
| E103 | ++ | − | − | − | − | − | − | − | − | − | − | − | − | − | − | − | − | − | − | − | − | − |
| E109 | + | + | − | − | − | − | − | − | − | − | − | − | − | − | − | − | − | − | − | − | − | − |
| E170 | + | − | − | − | − | − | − | − | − | − | − | − | − | − | − | − | − | − | − | − | − | + |
| E172 | + | − | − | − | − | − | − | − | − | − | − | − | − | − | − | − | − | − | − | − | − | − |
| CoNS Isolate | CoNS Isolate Identity | Areas of Interest Detected by BAGEL4.0 and Artemis Analysis |
|---|---|---|
| C14 | S. hominis |
|
| C33 | S. epidermidis |
|
| E4 | S. capitis |
|
| E6 | S. epidermidis |
|
| E54 | S. epidermidis |
|
| E67 | S. epidermidis |
|
| E89 | S. epidermidis |
|
| E96 | S. capitis |
|
| E99 | S. epidermidis |
|
| E100 | S. epidermidis |
|
| E170 | S. capitis |
|
| Isolate or Indicator Name in This Study | Isolate Identity |
|---|---|
| C1 | S. epidermidis |
| C4 | S. hominis |
| C5 | S. hominis |
| C7 | S. epidermidis |
| C9 | S. epidermidis |
| C14 | S. hominis |
| C15 | S. epidermidis |
| C19 | S. epidermidis |
| C20 | S. epidermidis |
| C31 | S. epidermidis |
| C32 | S. lugdunensis |
| C33 | S. epidermidis |
| C35 | S. epidermidis |
| C39 | S. warneri |
| C41 | S. capitis |
| C42 | S. epidermidis |
| C46 | S. epidermidis |
| C48 | S. epidermidis |
| C28 | S. capitis |
| E3 | S. epidermidis |
| E4 | S. capitis |
| E6 | S. epidermidis |
| E17 | S. epidermidis |
| E46 | S. epidermidis |
| E48 | S. epidermidis |
| E54 | S. epidermidis |
| E67 | S. epidermidis |
| E72 | S. epidermidis |
| E75 | S. epidermidis |
| E89 | S. epidermidis |
| E96 | S. capitis |
| E99 | S. epidermidis |
| E100 | S. epidermidis |
| E103 | S. epidermidis |
| E109 | S. epidermidis |
| E170 | S. capitis |
| E172 | S. epidermidis |
| MRSA B | S. aureus 0.0066 (IIIv) ST239 |
| MRSA C | S. aureus 0.1206 (Iv) ST250 |
| MRSA D | S. aureus 0.1239 (III) ST239 |
| MRSA E | S. aureus 0.1345 (llv) ST8 |
| MRSA F | S. aureus 0073 (III) ST239 |
| MRSA G | S. aureus 0104 (III) ST239 |
| MRSA H | S. aureus 0220 (ll) ST5 |
| MRSA I | S. aureus 0242 (Iv) ST30 |
| MRSA J | S. aureus 0308 (1A) ST247 |
| MRSA K | S. aureus 3045 (llv) ST8 |
| MRSA L | S. aureus 3144 (llv) ST8 |
| MRSA M | S. aureus 3488 (lvv) ST8 |
| MRSA N | S. aureus 3581 (IA) ST247 |
| MRSA O | S. aureus 3594 (II) ST36 |
| MRSA P | S. aureus 3596 (llv) ST8 |
| MRSA R | S. aureus E1038 (IIV) ST8 |
| MRSA S | S. aureus E1139 (IV) ST45 |
| MRSA T | S. aureus E1174 (Iv) ST22 |
| MRSA U | S. aureus E1185 (Iv) ST12 |
| MRSA V | S. aureus E1202 (II) ST496 |
| MRSA W | S. aureus M03/0073 (III) ST239 |
| M. luteus CIT3 | M. luteus |
| L. lactis HP | L. lactis |
Disclaimer/Publisher’s Note: The statements, opinions and data contained in all publications are solely those of the individual author(s) and contributor(s) and not of MDPI and/or the editor(s). MDPI and/or the editor(s) disclaim responsibility for any injury to people or property resulting from any ideas, methods, instructions or products referred to in the content. |
© 2024 by the authors. Licensee MDPI, Basel, Switzerland. This article is an open access article distributed under the terms and conditions of the Creative Commons Attribution (CC BY) license (https://creativecommons.org/licenses/by/4.0/).
Share and Cite
Twomey, E.; O’Connor, P.M.; Coffey, A.; Kiste, M.; Guinane, C.M.; Hill, C.; Field, D.; Begley, M. Inhibition of Clinical MRSA Isolates by Coagulase Negative Staphylococci of Human Origin. Antibiotics 2024, 13, 338. https://doi.org/10.3390/antibiotics13040338
Twomey E, O’Connor PM, Coffey A, Kiste M, Guinane CM, Hill C, Field D, Begley M. Inhibition of Clinical MRSA Isolates by Coagulase Negative Staphylococci of Human Origin. Antibiotics. 2024; 13(4):338. https://doi.org/10.3390/antibiotics13040338
Chicago/Turabian StyleTwomey, Ellen, Paula M. O’Connor, Aidan Coffey, Maija Kiste, Caitriona M. Guinane, Colin Hill, Des Field, and Máire Begley. 2024. "Inhibition of Clinical MRSA Isolates by Coagulase Negative Staphylococci of Human Origin" Antibiotics 13, no. 4: 338. https://doi.org/10.3390/antibiotics13040338
APA StyleTwomey, E., O’Connor, P. M., Coffey, A., Kiste, M., Guinane, C. M., Hill, C., Field, D., & Begley, M. (2024). Inhibition of Clinical MRSA Isolates by Coagulase Negative Staphylococci of Human Origin. Antibiotics, 13(4), 338. https://doi.org/10.3390/antibiotics13040338









